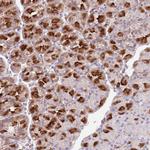
SNX6 Antibody in Immunohistochemistry (Paraffin) (IHC (P))

Search
Invitrogen
SNX6 Polyclonal Antibody
{{$productOrderCtrl.translations['antibody.pdp.commerceCard.promotion.promotions']}}
{{$productOrderCtrl.translations['antibody.pdp.commerceCard.promotion.viewpromo']}}
{{$productOrderCtrl.translations['antibody.pdp.commerceCard.promotion.promocode']}}: {{promo.promoCode}} {{promo.promoTitle}} {{promo.promoDescription}}. {{$productOrderCtrl.translations['antibody.pdp.commerceCard.promotion.learnmore']}}
产品信息
PA5-61948
种属反应
已发表种属
宿主/亚型
分类
类型
抗原
偶联物
形式
浓度
规格
纯化类型
保存液
内含物
保存条件
运输条件
RRID
产品详细信息
Immunogen sequence: RLGAAMMEGL DDGPDFLSEE DRGLKAINVD LQSDAALQVD ISDALSE
Highest antigen sequence identity to the following orthologs: Mouse - 89%, Rat - 87%.
靶标信息
SNX6 interacts with members of the transforming growth factor-beta family of receptor serine-threonine kinases. These receptors belong to two classes: type II receptors that bind ligand, and type I receptors that are subsequently recruited to transduce the signal. Of the type II receptors, SNX6 was found to interact strongly with ActRIIB and more moderately with wild type and kinase-defective mutants of TbetaRII. Of the type I receptors, SNX6 was found to interact only with inactivated TbetaRI. SNXs 1-4 also interacted with the transforming growth factor-beta receptor family, showing different receptor preferences. Conversely, SNX6 behaved similarly to the other SNX proteins in its interactions with receptor tyrosine kinases. Strong heteromeric interactions were also seen among SNX1, -2, -4, and -6, suggesting the formation in vivo of oligomeric complexes. These findings are the first evidence for the association of the SNX family of molecules with receptor serine-threonine kinases.
仅用于科研。不用于诊断过程。未经明确授权不得转售。
生物信息学
蛋白别名: Sorting nexin-6; TRAF4-associated factor 2; tumor necrosis factor receptor-associated factor 4(TRAF4)-associated factor 2; unnamed protein product
基因别名: MSTP010; SNX6; TFAF2
UniProt ID: (Human) Q9UNH7
Entrez Gene ID: (Human) 58533